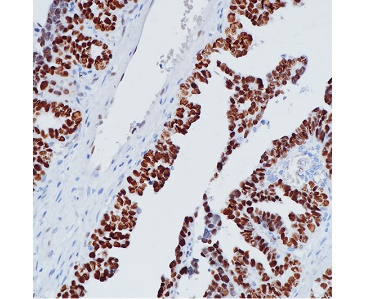

一抗选的好,免疫组化结果秒!
Immunohistochemistry of formalin fixed paraffin embedded human ovarian cancer using BeyoIHC™ WT1 monoclonal antibody at dilution of 1:200.

Immunohistochemistry of formalin fixed paraffin embedded human testis using BeyoIHC™ ACE2 monoclonal antibody at dilution of 1:200.
免疫组织化学(IHC)作为实验室经典技术之一
是科研人的必备实验技能
免疫组化耗时长,步骤多
为了得到特异性染色,获得可靠结论
选择合适的一抗十分关键
作为大家科研路上的忠实小助手
碧云天一次性推出了200余种IHC专属一抗
免疫与炎症相关,细胞骨架/细胞外基质相关
细胞代谢,细胞标志抗体,经典信号通路等种类多多
快来了解一下碧云天的BeyoIHC™系列抗体吧!
碧云天BeyoIHC™系列抗体是经过测试适用于免疫组织化学(IHC)的高品质抗体,也称病理抗体,很大一部分为重组兔单克隆抗体,通过先进的兔单克隆抗体技术平台研发并生产,无需获取动物的脾脏,仅需分离抗原特异性B细胞并通过基因工程方法克隆抗体基因,然后在哺乳动物细胞中重组表达并最终纯化获得。
产品特点:
BeyoIHC™抗体灵敏度更高,背景更低,染色更清晰,定位更精准:BeyoIHC™系列抗体通过反复的筛选和测试,确保灵敏度高、背景低、染色效果好;
BeyoIHC™抗体特异性更强,染色结果更为准确:BeyoIHC™系列抗体大部分都是精心筛选的高效价单克隆抗体,是由单个B细胞淋巴瘤表达,只针对一个抗原表位发生特定的免疫反应,应用于免疫组化时特异性更强,染色结果更为准确。
BeyoIHC™抗体一致性更好,批次间差异更小,结果重复性更好:BeyoIHC™系列抗体很大一部分是重组抗体,具有确定的抗体序列,使用不含任何动物源性物质培养液的哺乳细胞表达体系,生产的可重复性、一致性高,批次间差异小,可避免杂交瘤细胞制备过程中的基因丢失、基因突变和细胞株漂移等问题,所制备的重组抗体的重复性更好;
BeyoIHC™抗体提供免疫染色一抗稀释液:可以用于IHC检测或其它适当用途时的一抗稀释,进一步提高信噪比。
碧云天最新推出的BeyoIHC™抗体大致有如下分类:
| 免疫与炎症 | Bcl-6, BCMA, CD14, CD25, CD31, CD34, CD44, CXCR5… |
| 细胞骨架/细胞外基质 | Actin (Smooth Muscle), CD56, COL4A5, Cytokeratin 14, Desmin… |
| 染色质/表观遗传/细胞周期 | BRG1, CD2, c-Myc, Cyclin D1, ERG, p16, p53, SMAD4… |
| 细胞代谢 | AMACR, CD23, Estrogen Receptor (ER) α, hCG, TTF-1… |
| MAPK与PI3K/Akt通路 | ACE2, ALK, CD117, p120, ZAP-70… |
| 神经科学 | GFAP, Olig2, SOX10, Synaptophysin… |
| … | |
详细信息请扫码查看详情哦

相关产品:
